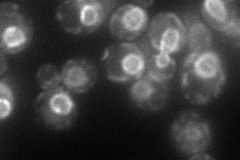

View description
One of two isozymes of HMG-CoA reductase that catalyzes the conversion of HMG-CoA to mevalonate, which is a rate-limiting step in sterol biosynthesis; localizes to the nuclear envelope; overproduction induces the formation of karmellae
Localization:
Intensity:
Fold change:
Significance:
-
C’ GFP library in SD

nuclear periphery47.2 -
N' NOP1pr-GFP in SD
ER,nuclear periphery69.4183 -
N' TEF2pr-mCherry in SD

ER,nuclear periphery134.491 -
N' NATIVEpr-GFP in SD

punctate,nuclear periphery47.6704 -
N' TEF2pr-VC and Cyto-VN in SD

ER,punctate39.0161 -
C’ GFP library in SD+DTT

nuclear periphery44.120.93No -
C’ GFP library in SD+H2O2

nuclear periphery57.681.22No -
C’ GFP library in Starvation Media

nuclear periphery43.390.91No -
C’ GFP library on the background of Pup2-DaMP

nuclear periphery -
C’ GFP library on the background of CCT mutant

nuclear periphery41.1470.871539No
